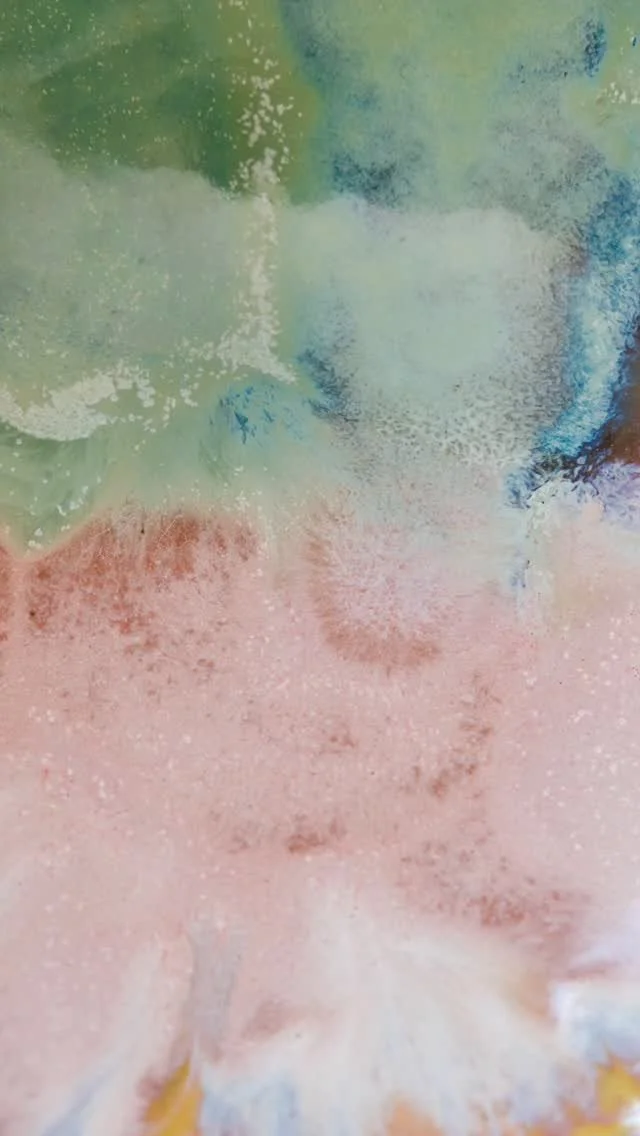

Woodfolk Top Picks
HONEST NATURAL MATERIALS
"Woodfolk believes in honesty, compassion and being kind to our environment.
We work in harmony with natural materials to create beautiful pieces for everyday wear, and that bring warmth and creativity into our homes."
Est. 2013.
----------------------